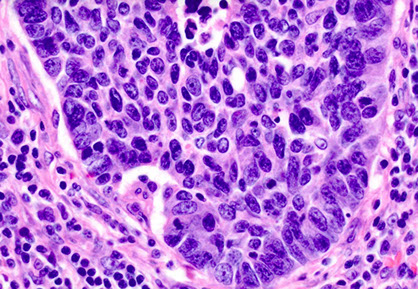
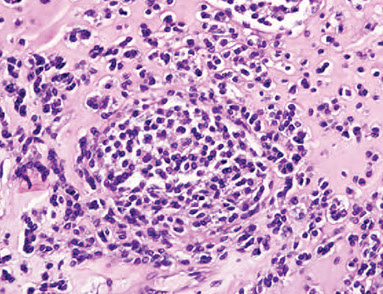

for more, refer to Respiratory cytology
Lung Non-neoplastic
Lung Neoplastic
Acute laryngitis
Chronic laryngitis
Pneumonia
Idiopathic Interstitial Pneumonitis
- NSIP, UIP, DIP, AIP, LIP, RBILD, COP, BOOP
Lung abscess
Peritonsillar abscess
Pulmonary Alveolar Proteinosis
Pulmonary eosinophilia
Malakoplakia
Obstructive Lung Diseases
- Asthma
- Chronic bronchitis
- Emphysema
- Bronchiectasis
Restrictive Lung Diseases
- Coal miner's pneumoconiosis
- Silicosis
- Asbestosis
- Berylium
- Hypersensitivity pneumonitis
- Idiopathic pulmonary fibrosis
- Sarcoidosis
Silo Filler's disease
Hot tub lung
Rheumatoid nodule
Talc granulomatosis
Acute Respiratory Distress Syndrome (ARDS)
Transfusion-Related Acute Lung Injury (TRALI) - see Heme/Onc - Transfusion
Neonatal respiratory distress syndrome (Hyaline membrane dz)
Pulmonary hypertension
Spontaneous pneumothorax
Tension pneumothorax
Atelectasis
Plexiform arteriopathy
Congenital Cystic Adenomatoid Malformation (CCAM)
Minute Meningothelial-like Nodule
Epithelial Tumors
-
Adenocarcinoma
- Mucinous, Nonmucinous
-
- Genes (EGFR, KRAS, ALK)
- Lepidic, Acinar, Papillary, Micropapillary, Solid, Invasive mucinous, Colloid, Fetal, Enteric, Minimally invasive (mucinous and nonmucinous), Preinvasive (Atypical adenomatous hyperplasia, Adenocarcinoma in situ)
-
Squamous cell
- Keratinizing, Non-keratinizing, basaloid
- Neuroendocrine tumors
-
- Small cell (oat cell) carcinoma; Large cell carcinoma; Large cell neuroendocrine carcinoma; (Bronchial) Carcinoid tumor; Adenosquamous carcinoma; Sarcomatoid carcinomas (Pleomorphic, Spindle cell, Giant cell, Carcinosarcoma, Pulmonary blastoma); Lymphoepithelioma-like ca; NUT carcinoma; Salivary gland-type tumors; Papillomas (Squamous cell, Glandular); Adenomas (Sclerosing pneumocytoma, Alveolar adenoma, Papillary adenoma, Mucinous cystadenoma, Mucous gland adenoma)
Mesenchymal Tumors
- Hamartoma;; Epithelioid hemangioendothelioma; PEComatous tumors (Lymphangioleiomyomatosis); Congenital peribronchial myofibroblastic tumor; Diffuse pulmonary lymphangiomatosis; Inflammatory myofibroblastic tumor; Pleuropulmonary blastoma; Synovial sarcoma; Pulmonary artery intimal sarcoma; Pulmonary myxoid sarcoma c EWSR1-CREB1 translocation; Myoepithelial tumors (Myoepithelioma; Myoepithelial ca)
Lymphohistiocytic tumors
- Extranodal marginal zone lymphomas of mucosa-associated lymphoid tissue (MALT lymphoma); Diffuse large cell lymphoma; Lymphomatoid granulomatosis;
- Intravascular large B cell lymphoma; Pulmonary Langerhans cell histiocytosis
- Erdheim-Chester disease
Tumors of ectopic origin
-
Germ cell tumors
- Mature and immature teratomas
- Intrapulmonary thymoma
- Melanoma; Meningioma, NOS
Metastatic tumors
Pleura Neoplastic
Mesothelioma
Solitary Fibrous Tumor (SFT)
Pleuropulmonary blastoma
Lung Basics
Embryology
asdf
Anatomy
asdf

Histology
asdf



Sampling Techniques
Flexible Bronchoscope
asdf
Endobroncial Bx
asdf
Transbronchial Bx
asdf
Endobronchial bx

Transbronhial bx

Flexible Bronchoscope

Transbronchial Needle Aspiration (TBNA)
- aspiration of peri-airway tissue (LNs)
- sarcoidosis
- Lung ca staging (not very sensitive, can map LNs b CT, lesions are blindly sampled, ROSE increases diagnostic yield of TBNA
Radial EBUS

Curvilinear / Convex EBUS

EndoBronchial Ultrasound (EBUS)
2 imaging modalities:
1) Curvilinear EBUS
2) Radial EBUS
- probe passes through channel of bronchoscope
- - real-time 360 degree planar imaging perpendicular to probe of peri-airway structure
- ensures in correct vicinity of peripheral lesion
Minimally Invasive lung ca staging
- used to be done c cervical mediastinoscopy (CMED), invasive LN excision c 2% major morbidity, ~1% mortality, expensive
EBUS-TBNA minimally invasive, access to more node stations, dx and stage in single procedure, can do ancillary testing c material
Transthoracuc CT-guided CNB/FNA
= peripheral lesions
- 90%+ sens/spec
- up to 1/3 get pneumothorax, some bleeding
- mesothelial cells can contaminate specimen
Electromagnetic Navigational Guidance Bronchoscopy (ENB/SuperD)
- software makes 3d virtual bronchial tree from hrCT scan, external sensors help c probe localization
- inc accuracy of peripheral lesions
- less risk of pneumothorax (~3% vs up to 20%)
- cost about same as CT-FNA
ENB Core Biopsy Alternative
Blunt tip rotates and shears tissue in frags, getting more tissue per pass and bigger tissue fragments

ENB Core bx alternative

Cryoprobe
for bigger tissue fragments
- Joule-Thomson effect (rapid expansion of compressed CO2 making very low temp at probe tip)
Lung Non-neoplastic
Acute laryngitis
Inflam of larynx; common cause of hoarseness; may present w URI sx
- MCC: viral (such as Moraxella catarrhalis or H. influenza)
Tx: rest voice to avoid formation of vocal nodules; humidified air clears secretions
- antihistamines and corticosteroids not effective
Chronic laryngitis
Laryngitis > 3 weeks
Caused by vocal overuse (prof vocalists), chemical irritation, GE reflux, allergic rhinnitis or nasal post-drip
~ persistent acute laryngitis evaluated w laryngoscopy (should see inflam changes)
Tx: Underlying cause (vocal cord rest, smoking cessation)
- Abx used in Sinusitis, H2 blockers for GERD, inhaled roids for allergic dx
Pneumonia
Inflammation of the lung parenchyma
Types: 1) Lobar, 2) Bronchopneumonia (Lobular), 3) Interstitial (atypical)
1) Lobar
Consolidation w/in a lobe; affects a large and continuous area of a lung lobe
- may affect entire lung and cause empyema
Strep Pneumococcus is the MCC of Community-Acquired Pneumonia (CAP); Klebsiella there too sometimes
PE: Bronchial breath sounds over lesion; dullness to resonance; inc fremitus; no tracheal deviation
2) Lobular (Bronchopneumonia)
Caused by S. aureus, H. flu, Klebsiella, S. pyogenes, Legionella
Look for sudden onset of very high fever, productive cough (from alveolar exudates)
Looks "patchy" w multiple foci of isolated acute consolidation in >= 1 lobe; scattered consolidation (past the terminal bronchus)
- signs of consolidation: Dull nodes to percussion, inc tactile fremitus
- Acute inflam infiltrates from bronchioles into adjacent alveoli
3) Interstitial (atypical) "Walking" pneumonia
Insidious (Indolent) onset; No consolidation, Non-productive cough; interstitial inflam withOut exudate
- diffuse patchy inflam localized to interstitial areas of alveolar walls involving > 1 lobe
Causes: Viruses (RSV, adenoviruses), Mycoplasma (MCC), Legionella, Chlamydia (C. pneumo 2nd MCC atypical pneumo)
*** WaLCing pneumonia *** for Mycoplasma, Legion., Chlam
- Mycoplasma pneumo --> Bullous myrangitis (inflam of middle ear w oozing blisters) + cold autoimmune hemolytic anemia from cross-reactive IgM abs
- may see hyponatremia with Legionella
- see C. psitacci in pet shop owners (get it from birds); C. trachomatis in newborns with staccatto cougg, conjunctivitis, and wheezing
Recurrent pneumonia in the same lobe? --> Get a CT bc something is probably blocking!
Pulse - temperature dissociation: Normal pulse with a high temp.
Tx:
Outpatient: Macrolides (azithro- clarithromycin) or Doxycycline
- if pt has comorbidities, add fluoroquinolones (levo-/ moxifloxacin)
Inpatient: Fluoroquinolones or Ceftriaxone PLUS Doxycycline
Hospital acquired pneumonia (starts >= 72 hours post admission): Cefipime/ Ceftazidime, Piperacillin/ Tazobactam (antipseudomonals), Imipenem (may cause seizures)
- MCC hospital acqd pneumonia: S. aureus
- if pt on ventilator, add 2nd antipseudomonal PLUS vancomycin / linezolid
Pneumonia in an AIDS pt? --> thing Pneumocystis --> give TMP/SMX
- if PCP severe, Roids dec mortality! (? how?)
Histoplasma
- see Mycology for details
Associated with aerosolized bird or bat guano esoecially in the Ohio or Mississippi river valleys
H. capsulatum antigen testing in urine is useful for rapid evaluation of individuals with pulmonary disease following inhalation of a large quantity of organisms or those with possible disseminated disease
- the test may cross react with other fungal organisms, such as Blastomyces




Nonspecific Interstitial Pneumonia (NSIP)
Non-specific interstitial pneumonia (NSIP) is a form of idiopathic interstitial pneumonia
Patients with an NSIP histologic pattern on biopsy have a better prognosis than those with usual interstitial pneumonia (UIP)
- temporally uniform
2 variants of NSIP: cellular and fibrosing
1) cellular variant features chronic inflammatory cells in interstitium with minimal collagen deposition
2) fibrosing pattern consists of diffuse interstitial fibrosis with fewer inflammatory cells
Micro: underlying lung structure is maintained
- honeycomb change and fibroblast foci are minimal, if at all
- prominent pneumocyte hyperplasia seen
In contrast to UIP, NSIP has little or no honeycomb change, and fibroblast foci are scant or absent
Px: fibrotic NSIP is worse than cellular NSIP, but both are better than UIP

NSIP
Pathology in nonspecific interstitial pneumonia (NSIP)
(A) Cellular pattern, alveolar walls thick c uniform, cellular, inflam interstitial infiltrate; lung architecture preserved. Has small foci of organizing pneumonia
(B) Cellular pattern; cellular infiltrate mostly lymphs and a few plasma cells.
(C) Fibrosing pattern. uniform alveolar walls thickening by interstitial fibrosis; connective tissue appears same age. No honeycombing or fibroblastic foci.
(D) Fibrosing pattern; alveolar wall thickened by dense interstitial fibrosis and few chronic inflam cells; overlying pneumocytes c cuboidal hyperplasia. A few alveolar macrophages are present.
(E) Interstitial fibrosis with airspace enlargement and surrounded by mild to moderate interstitial fibrosis. In contrast to the typical honeycombing of usual interstitial pneumonia, lung architecture is generally preserved. Mucus present within some of these airspaces.
(F) Interstitial fibrosis with airspace enlargement. Bronchioles are dilated. Diameter of larger bronchiole is about 2x that of adjacent muscular pulmonary artery, indicating traction bronchiolectasis. The surrounding alveolar walls are fibrotically thickened but the lung architecture is generally preserved.
Usual Interstitial Pneumonia (UIP)
Pts > 50 yo, smokers, chronic dz that may result in death after ~5 yrs of respiratory failure; MCC idiopathic interstitial pneumonia, M>F
- aka Idiopathic Pulmonary Fibrosis (IPF) by imaging
- assoc c lots of other dzs, may be genetic; usually find circulating immune complexes
- Repeated cycles of epithelial injury --> abnormal epithelial repair --> fibrosis --> dec diffusion --> hypoxemia and dec/normal CO2
- PFTs: restrictive w dec diffusion capacity
H/P: Fever, dyspnea, chronic nonproductive cough
- may be assoc c hypersensitivity pneumonia and CT dz
CXR: ground glass or honeycombed (also seen in Langerhans histiocytosis X) appearance w/ reticulonodular infiltrates, or may be normal
Micro: Irregular, non-uniform scarring throughout interstitium with perilobular accentuation and spared alveoli at center of lobule, "old" fibrosis, honeycombing, fibroblastic foci (young fibrosis)
- form fibroblastic tufts, which may be the cause of the spread of dz
- has marked heterogeneity in degree and type of inflam, and spatial and temporal distribution of fibrosis
- late stages has honeycombing (on gross) c bronchiolar metaplasia of alveoli
- for Definitive DX: Lung bx ( a dx of exclusion)
No tx; rapidly decline; 3-7 yr life expectancy
Px: usually fatal
UIP

UIP/IPF - white tissue is interstitial fibrosis

UIP with patchwork distribution of fibrosis, fibroblastic foci (upper left), and honeycomb pattern (lower right)`

Acute Interstitial Pneumonia (AIP)
aka Hamman-Rich syndrome
- rapidly progressing dz in young adults after flu-like dz, is an idiopathic pneumonia
Micro: appears similar to organizing DAD, has lots of interstitial fibroblastic proliferation
Px: poor, most die in 2 mo
Lymphocytic Interstitial Pneumonia (LIP)
Uncommon form of interstitial lung dz, usually seen c AIDS (is an AIDS-defining illness in children), Sjogrens, or other form of immune dysregulation
- MC AIDS-defining illness in kiddos
Mciro: dense and diffuse alveolar septal (interstitial) lymphoplasmacytic chronic inflam and scattered histiocytes
- germinal centers may be prominent
- small loosely formed nonnecrotizing granulomas are often present
-- not usually considered a granulomatous dz
- should be differentiated from LG B-cell lymphomas
LIP

Desquamative Interstitial Pneumonia (DIP)
Highly assoc c cigarette smoking
Micro: uniform, diffuse intra-alveolar and small airspace pigmented macrophage accumulation +/- interstitial fibrosis
Tx: responds well to smoking cessation and steroids
DIP c alveolar spaces diffusely involved by marked alveolar macrophage accumulation and mild interstitial thickening`

Respiratory Bronchiolitis Interstitial Lung Disease (RB-ILD)
Middle aged men that smoke (considered a "normal" finding in smokers; rarely symprommatic
Histo: Intra-alveolar accum of macrophages with minor interstitial thickening
Imaging: ground glass opacification bilat at lung base and centrilobular nodules
Tx: roids
RB-ILD

Bronchiolitis Obliterans-Organizing Pneumonia (BOOP)
- aka Organizing Pneumonia (OP)
Airspace-filling, active fibrosing process involving the distal bronchioles, alveolar ducts and alveoli in varying proportions, commonly seen c aspiration
- clinically has Restrictive PFT results
- subacute onsetand some pts have hx pf recent RTI
- assoc c infx, rx (gold, bleomycin, inhalers), rads, collagen vascular dz, eosinophilic / hypersensitivity/ nonspecific interstitial pneumonia
Micro: fibroblastic plugs ("Masson bodies") that fill air spaces that are elongated, lots of foamy macros
- appears patchy on low power
DDx: interstitial pneumonia, which have temporal and spatial heterogeneity and is interstitial (rather than intraluminal), and are always assoc c architectural distortion in form of scarring and honeycomb lesions
Px: very good (unless steroids don't work)
BOOP


Cryptogenic Organizing Pneumonia (COP)
Organizaing pneumonia with no defined cause (idiopathic)
- essentially an idiopathic BOOP
- usually multifocal and patchy
- seen in Chronic airway rejection (lung transplant), GVHD, infx (adenovirus), toxic, connective tissue dz
Imaging: ground-glass, patchy, peribronchial nodules
IHC: can do elastin stain which highlights bronchiole obliterated by scar tissue

Obliterative Bronchiolitis
- aka Constrictive Bronchiolitis Obliterans
Usually seen in lung allograft recipients as a manifestation of chronic rejection but also caused by chronic airway rejection (as in lung transplant), GVHD (in bone marrow transplant), infx (adenovirus), drugs, and connective tissue dz
- shows obstructive Pulmonary Function Tests (PFT)
- PFTs: Obstructive
Micro: Submucosal scars in bronchioles
- peribronchiolar fibrosis assoc c luminal narrowing
Obliterative Bronchiolitis: subepithelial fibrosis (arrow) resulting in distortion of bronchiolar lumen (Bar=82 um)

Hypersensitivity Pneumonia
- aka extrinsic allergic alveolitis
Immunologic rxn in inhaled ag, usually organic ag
- common exposures include avian proteins (pigeon-breeders' lung, bird fancier's lung) and various molds and bacteria (farmer's lung)
Triad:
1) foci of bronchiolitis obliterans
2) Non-necrotizing granulomas in peribronchiolar interstitium
3) temporally uniform, cellular, chronic interstitial pneumonia c peribronchiolar accentuation
-- occasionally in chronic cases, histologic features can overlap c usual interstitial pneumonia (UIP) but the presence of chronic bronchiolitis and granulomas can help in the distinction
Hypersensitivity pneumonia

Lung abscess
Localized collection of foul-smelling pus in parencyma
- Empyema = pus w/in pleural space
- MC organisms: S aureus or anaerobes
- usually caused by bronchial obstruction (eg cancer) or from aspiration of oropharyngeal contents (esp in pts predisposed to LOC [alcoholics {esp Klebsiella}, and epileptics])
~ if caused by aspiration, abscess usually found in Right Lower Lobe
May become complicated by fibrosis or fistulas
See air-fluid levels on CXR (best initial test); also get CBC, ABG and pulse ox
- sputum culture not necessary to dx
Tx: Clindamycin, US-guided aspiration
Aspiration pneumonia - under-diagnosed clinically (maybe only 1/10 dx'd correctly clinically); may look like carcinoma, can be a solitary nodule; risk factors are obesity, drug use, prior gastric surgery. Histology shows necrotizing granulomas in response to foreign material (food)

Peritonsillar Abscess
Usually a complication of recurrent pharyngitis / tonsillar infx (seen more in peds)
Common causes: B-hemolytic strep and anaerobes (Fusobacterium)
The kid looks TOXIC (like epiglottitis)
Dx: CT
Tx: IV fluids and abx; I & D (may require tonsillectomy [try to aspirate first w needle!]), send pt home on Amoxicillin or Augmentin (have good B-lactam coverage)
Pulmonary Alveolar Proteinosis (PAP)
Pt presents c cough filled c gooey stuff
Defect in macrophages that causes accumulation of surfactant-like material in the alveolar space
- can be autoimmune, secondary silica/aluminum exposure, blood cancer, immunologic dz, infection, or congenital
- though assoc c surfactant deficiency (?)
- has been assoc c Nocardia infx
- the exudate in Pneumocystic pneumonia is foamier compared to PAP
- 2/2 auto-abs to GM-CSF, which neutralize GM-CSF, interfering with alveolar macrophage development and causing buildup of excess surfactant
- mutation in surfactant protein B seen in congenital form and is fatal
Micro: Homogenous clumpy pink granular in the alveoli c little inflam
IHC: material is PAS-(+) diastase resistant
Tx: Whole lung lavage; GM-CSF
Pulmonary Alveolar Proteinosis (PAP)


Pulmonary eosinophilia
- or eosinophilic pneumonia
- Reaction to drugs, Aspergillus or other fungi
- Assoc with chronic asthma, usually in the setting of allergic bronchopulmonary aspergillosis (ABPA)
Simple (Loeffler syndrome)
- mild, self-limited condition
Acute
- Acute respiratory insufficiency
- DAD with prominent eosinophilia
Chronic
- subacute illness
- airspace consolidation
-- histiocytes
-- eosinophils
Gross: consolidation, mucus plugs in distal bronchi or bronchioles
Micro: patchy intra-alveolar edema, interstitial inflammation with giant cells and eosinophils with scattered histiocytes and plasma cells
- mucus plugs composed of inflammatory cells and cellular debris
- Charcot-Leyden crystals can be seen
- often bronchiolitis obliterans
- blood vessel infiltration by inflam cells common, but no vascular necrosis
- no diffuse alveolar damage
DDx:
- Langerhan cell histiocytosis, chronic eosinophilic pneumonia is airspace filling and is composed of alveolar macrophages and eosinophils
- Langerhan cell histiocytosis is interstitial and made of Langerhan cells and eosinophils
Eosinophilic Pneumonia

Pleuroparenchymal Fibroelastosis (PPFE)
Micro: intense fibrosis of visceral pleura
- prominent, homogenous, subpleural fibroelastosis
- sparing of the parenchyma distant from the pleura
PPFE

Pulmonary Allograft Rejection
Revised Working Formula (2007)
A.) Acute rejection
B.) Airway inflam
C.) Chronic airway rejection
- obliterave bronchiolitis
D.) Chronic vascular rejection
- accelerated graft vascular sclerosis
A) Acute Rejection
A1 (minimal)
perivascular mononuclear cell infiltrates 2-3 cells thick
A2 (mild)
Perivascular infiltrates, >3 cells thick
A3 (moderate)
Perivascular infiltrates similar to A2, with extension into alveolar septa
A4 (severe)
Diffuse mononuclear cell infiltrates, similar to A3 c lung injury, also have acute lung injury (ALI)
Airway Inflammation
Chronic Airway Rejection (obliterative bronchiolitis)
Chronic Vascular Rejection
- accelerated graft vascular sclerosis
Moderate acute perivascular rejection


Severe BPD
BPD


Bronchopulmonary Dysplasia (BPD)
Bronchiolitis obliterans (necrotizing bronchiolitis) seen in acute phase
Chronic phase shows submucosal fibrosis, mucous gland atrophy, and squamous metaplasia
Mucoid Impaction of Bronchi (MIB)
Allergic mucin with necrotic bands of eosinophils and Charcot-Leyden crystals
- highly suggestive of allergic bronchopulmonary aspergillosis (ABPA) -- esp Apergillus fumigatus
Micro: scattered fungal hyphae can be found in the intraluminal mucin
Px: recurrences are common, and progressive lung fibrosis can develop if untreated
Mucoid Impaction of Bronchi (MIB)

Diffuse Idiopathic Pulmonary Neuroendocrine Cell Hyperplasia (DIPNECH)
Generalized prolif of pulmonary NE cells confined to mucosa of airways or can form aggregated (tumorlets) usually < 5 mm
- usually assoc c mild chronic inflammation or fibrotic lung injury,
Px: can sometimes turn into typical carcinoid tumor or rarely atypical carcinoid tumor
- aggressive NE tumors (large cell neuroendocrine tumor and small cell carcinoma) have not been seen with DIPNECH
DIPNECH

Malakoplakia
Aggregation of histiocytes that can cause grossly appreciated nodules
- have Michaelis-Gutmann bodies, full of Ca2+ and Fe
- pts frequently immunosuppressed (c AIDS) and get Rhodococcus equi or E coli infx
DDx: other histiocytic lesions of lung (Rosai-Dorfman, Erdheim-Chester, Langerhans cell histiocytosis
Obstructive Lung Diseases
Asthma
Bronchial hyperresponsiveness causes reversible bronchoconstriction
- may be caused by allergens, URIs, or stress
~ PFTs req'd for dx!!
3 forms: 1) Atopic, 2) Non-atopic, 3) drug induced
Micro: smooth muscle and gland hypertrophy; inc vascularity and inflam, Curschmann's spirals (shed spithelium from mucus plugs), inc eosinophils
- Charcot-Leyden (CL) crystals assoc w/ parasites
PE findings: wheezing, cough, dyspnea, tachypnea, hypoxemia, dec I/E ratio (b/c inc Expiration), pulsus paradoxus
__________________________________________
Tx
Steps for trying drugs when dealing w/ an acute exacerbation:
1. SABA
2. Low dose steroid +/- Chromium/ Nedocromil, theophylline, LT modifiers
3. LABA or inc Roids
4. Max Roids + LABA
5. Everything + omalizumab
6. Oral roids
Bronchoconstriction caused by inflam and sympathetic tone
B agonist toxicity: tachycardia and hypokalemia
- less toxic if aerosolized
Isoprotenerol: Nonspecific B agonist. B2 stim produces desired effect of relaxing sm muscle in bronchi, bust advsersely stim B1 causing tachycardia.
*** ISO NO! (I DOn kNOw!) *** Isoprotenerol is nonspecific
Albuterol, Terbutaline, Metaprotenerol : B2 Agonists. Used during acute asthma exacerbation, using the B2 receptor to increase cAMP and relax smooth muscle in the bronchioles
- Fast onset, short T1/2 (~ 4 hrs)
Levalbuterol is an enantiomer of albuterol; doesnt stim B1
Salmeterol - Long Acting B2 agonist (>12 hrs)
- adverse effects are tremor and arrhythmia
*** Touching that long salmon causes you to tremble ***
- activate Gs --> inc cAMP --> bronchodilation
*** ATM = fast acting B2 agonists **** Goto the ATM fast, B!!! *****
Theophylline ( a methylxanthine) inhibits PhosphoDiEsterase (PDE) causing inc cAMP through dec cAMP hydrolysis.
- Narrow therapeutic index due to cardio- and neurotoxicity; like caffeine it also causes abdominal pain, vomiting, and seizures
- metabolized by p-450
- Blocks adenosine receptor (causes broncodilation): Used in nocturnal asthma prophylaxis and unresponsive asthma
- Causes an INC in: Lipolysis, glycogenolysis, gluconeogenesis, and epi release from adrenal medulla
Ipratropium (Muscarinic antagonist): competitively blocks muscarinic receptors, preventing bronchoconstriction
- used in COPD
Nedocromil (Cromolyn sodium): Blocks degranulation of mast cells, but only good for prevention, not during acute exacerbations.
- Toxicity is rare b/c of low systemic absorption
Flunisolide, Budesonide, Beclomethasone, prednisone (corticosteroids): Inhibits cytokine synth; inactivates NF-kB [dec PhosphoLipase A2 (PLA2)], which dec TNF-a production (and the rest of inflam mediators).
- 1st line tx for chronic asthma, and for allergic rhinnitis; used mostly for asthma maintenance; often used in COPD too
- interesting toxicities: Oral Candida (not very toxic); may cause Cushingoid changes
Zileuton: inhibits 5-lipoxygenase, thus blocking arachidonic acid --> LeukoTriene (LTD4; fast onset) conversion
Zarfirlukast, monteleukast: Block leukotriene receptor
- use in aspirin-induced / exercise- induced asthma
- monteleukast is better for kids; but is hepatotoxic and assoc w/ Churg-Strauss
***Kast = Last *** Blocks the Last step in LT binding ***
Omalizumab (anti-IgE abs): Recombinant humanized IgG1 monoclonal Ab that binds w/ IgE to inhibit action of IgE w/ its Fc receptor on mast cells, basophils, and other cells to dec allergic mediators in Type I HS
~ over time, leads to dec IgE circulating ( only useful in pts w/ proven IgE sensitivity
- Useful in asthmatics refractory to steroids
*** The only vowel omolizumab doesnt have is "E" --> blcks IgE!!!***
Normal inspiration flow pattern, but air flow gets obstructed, resulting in air trapping; airways collapse (close) premature; inc RV, dec FVC; but because FEV1 is super dec, FEV1/FVC < 80% (important!); V/Q mismatching present
MC complication: COPD exacerbation --> URTI, dec CV function, pollutants cause dec PFTs and require hospitalization and mech ventilation
Asthma - hyperexpanded pink lungs

Acute asthma acerbation with cartilage on right and bronchial lumen filled with eos and mucus (inset). There is some edema and hypertrophy in the smooth muscle adjacent to the cartilage


Chronic Obstructive Pulmonary Disease (COPD)
aka Chronic Obstructive Lung Disease (COLD)
The two major forms are chronic bronchitis and emphysema; these can co-exist
- usually due to cigarette smoking
Chronic bronchitis ("blue bloater")
early hypoxia --> pulmonary vasoconstriction --> inc afterload --> RV failure (cor pulmonare)
- cor pulmonare due to hypoxia!
paCO2 chronically elevated
~ produce large amounts of sputum
Bronchiolar Goblet cell (mucus-secreting gland) hypertrophy
- Reid index ( [gland depth] / [total thickness of bronchial wall]) > 1/2
Look for productive cough for >3 consecutive months in >= 2 years
Findings: wheezing, crackles, cyanosis, late-onset dyspnea
- CXR: prominent vessels, large heart
Emphysema
- "Pink puffer", barrel-shaped chest
Enlargement of air spaces and dec recoil (inc elastase activity) resulting from destruction of alveolar walls
- Inc compliance due to loss of elastic fibers --> barrel-shaped chest
Findings: dec breath sounds, tachycardia, late-onset hypoxemia (vs early in chronic bronchitis) due to eventual loss of capillary beds ( occurs w/ loss of alveolar walls), early onset dyspnea
Death from: 1) Respiratory acidosis and hypercapnic respiratory failure, 2) Massive pneumothorax, 3) Cor pulmonare (rarely) from dec O2
- Centroacinar: think Cmokin' (smoking); dilates respiratory bronchioles; mostly in upper lung
- Panacinar: a1-antitrypsin def (or liver cirrhosis for that matter); entire acinus is involed; mostly in lower lung fields
- Paraseptal emphysema: assoc w/ bullae --> can rupture --> cause spontaneous pneumothorax in young adult males; adjacent to pleura
CXR: hyperlucent lung fields, flattened diaphragm, tubular shaped heart
- pursed-lip expiration to inc airway pressure and prevent airway collapse`
Emphysema - note the bullae and blebs, anthracosis, and that the lungs almost meet in the midline

Bronchiectasis
Chronic necrotizing infection of bronchi --> permanently dilated airways, purulent sputum, recurrent infx., hemoptysis
- assoc w/ bronchial obstruction, Cystic Fibrosis (MCC [50%]), ciliary motility, and Kartagener's syndrome
~ may develop aspergillosis
Bronchioles have NO cartilage, instead replaced w/ prominent smooth muscle
Dx: High resolution CT (most accurate)
- similar to amyloidosis b/c both have proteinuria
Tx: rotate abx; chest clapping
- N-acetylcystein and guaifenesin dec viscosity of secretions
- freq take fluoroquinolones for pseudomonas
Restrictive Lung Diseases
dec pulmonary compliance, inc lung elasticity
dec lung volumes (FVC and TLC)
- FEV1/FVC ratio > 80%
Pathophysiology: 1) Poor breathing mechanics, 2) Interstitial lung dz
1) Poor breathing mechanics (extrapulmonary, peripheral hypoventilation): Poor muscular effort (polio, myasthenia gravis); poor structural apparatus (scoliosis, morbid obesity)
2) Interstitial lung dz (pulmonary, lowered diffusing capacity): ARDS; Neonatal respiratory distress syndrome (hyaline membrane dz); pneumoconiosis (coal miners, silicosis, asbestosis); sarcoidosis; idiopathic pulmonary fibrosis; Goodpasture's syndrome; Wegner's granulomatosis
Coal miner's pneumoconiosis
Assoc w/ coal miners; remains asymptomatic for 20-40 years; late stage w/ focal emphysema and fibrosis
- caused by carbon deposition (which is usually inert)
- called "complicated" CMP when there is progressive massive fibrosis that causes dec in pulmonary function
No inc risk for TB or cancer, but may result in cor pulmonare or Caplan's syndrome (rheumatoid nodules)
- affects upper lobes
No Tx
Hard Metal Pneumoconiosis


Hard Metal Pneumoconiosis
Cobalt and tungsten
Micro: giant cell interstitial pneumonia,2 types of macrophages: alveolar macrophages (c emperipolesis) and epithelioid giant cells (made of type II cells, TTF +)
Silicosis
Silicosis assoc w foundries, sandblasting, and mines
- Macros respond to silica and release fibrogenic factors, leading to fibrosis; thus may disrupt phagolysosomes and impair macros (can no longer ingest bugs like mycobacterium), causing inc susceptibility to TB.
- nodular fibrosis; PFTs usually normal; mostly in upper lobes, relatively diffuse; tracks along lymphatics
Micro: silica best seen in polarized light
- interacts w free radicals and causes membrane damage
~ crystalline form esp pathogenic
- See "eggshell calicifications" of hilar lymph nodes on CXR
Asbestosis
2 types: 1) Amphibote ( smaller and more dangerous!!!), 2) Serpentine: Curled --> get stuck
- synergist inc risk w/ smoking for Bronchogenic ca., NOT mesothelioma (though is linked to mesothelioma)
- acquired from shipbuilding, roofing, and plumbing
- MC dz related to asbestos exposure is pleural plaques, tho can also cause mesothelioma, bronchiogenic ca, pleural effusions and parenchymal interstitial fibrosis
Imaging: See "ivory white" pleural plaques on CXR; affects lower lobes (*** Iron weighs more than the rest!***)
- presents as interstitial pneumonia; get bilat end-inspiratory crackles at bases
Asbestos bodies are golden-brown fusiform rods resembling dumbbells located in macros that are called ferruginous / asbestos bodies after being coated with the body's endogenous iron
***Ferruginous bodies = Fe {iron}***
- Macros eat asbestos --> lung inflam; calc of pleura and diaphragm --> pleural plaques
Beryllium
Found in fluorescent light bulbs, space craft, heat shields on nukes
- Aggressive --> cancer
- large granulomas, resembling sarcoidosis
Hypersensitivity pneumonitis
Interstitial lung dz w/ interstitial pneumonitis and non-caseating granulomas
- exposure to inhaled irritants (occurs 4-6 hours after exposure) --> serious chronic fibrotic lung dz (restrictive)
MCC: farmer's lung + in pidgeon breeders;
Farmers lung: Thermophilic actinomyces (found in hay)
-- causes an acute HS pneumonitis w/ marked fever, rigors, dyspnea and cough several hours post exposure
--- may be confused w pneumonia or influenza; chronic dz has patchy fibrosis ( like sarcoid)
~ Type III or IV HS
- histological changes in bronchioles
Chronic (either CHP or EAA [synonymous terms]) form may lead to respiratory failure
- IgG and cell-mediated
Micro: small non-necrotizing granulomas; has prominent interstitial chronic inflam
- scattered small poorly formed granulomas or MNGCs in interstitium
- some have BOOP component
Tx: 1) Remove Irritant; 2) Roids
- CHP without fibrosis is most responsive to roids
Hypersensitivity pneumonitis. The main abnormality is mild thickening of the alveolar septa (interstitium). Granulomas are not visible at this mag.

Hypersensitivity pneumonitis. Interstitial chronic inflam c a loose cluster of histiocytes (poorly formed granulomas)

Sacroidosis. Granuolomas are distributed along the pleura (top), interlobular septum (arows) and bronchovascular bundles (arrowhead). ("lymphangitic distribution"). The inflam is localized to the granulomas and does not extend intto the adjacent lung parenchyma

Sarcoidosis. Well-formed, non-necrotizing granuloma surrounded by characteristic concentric fibrosis


A. Asteroid body (endogenous) in sarcoidosis. B crystalline inclusion (endogenous) in sarcoidosis (the inclusion is birefringent [inset])
Sarcoidosis
Multisystem granulomatous dz c no known etiology; mostly in middle-aged black women
- can present c perihilar nodal dz w/o lung involvement, diffuse lung dz w/o LN involvement on imaging, or a mix of both
-- can be dx'd w/o bx if pt has Lofgren's syndrome, Heerfordt's syndrome, or asx bilateral hilar lymphadenopathy
Imaging: lambda or panda sign on gallium uptake
Histo: patchy, nonnecrotizing granuloma c epithelioid cells, Langerhans GC, activated macrophages, Th cells
- granulomas usually in interstitium of lung (not in air spaces) or around vessels; follows lymphatics
- necrotizing sarcoid granulomatosis is diffusely infiltrative and destructive
- Hamazaki-Wesenberg bodies: small oval tan bodies in sinusoidal spaces of LNs that are Giemsa (+)
- other intracytoplasmic "bodies" made of calcium are asteroid bodies, Schaumann bodies and conchoid bodies
Silo Filler's disease
Exposure to nitrogen dioxide
- may lead to ARDS, not immunologically mediated
Hot Tub Lung
Usually in younger female or male pts
- also must have history of hot tub use
- a type of hypersensitivity rxn
- hot tub infected by Mycobacterium avium complex (MAC)
Micro: non-necrotizing granulomas within bronchiolar lumens
Hot tub lung. The granulomas show a predilection for the bronchioles

Lady Windermere Syndrome
Usually elderly woman w/o hx of smoking or pre-existing lung dz
- possibly from voluntary suppression of forceful coughing that can lead to post-obstructive pneumonitis, pulmonary fibrosis or focal bronchietctasis
Imaging: Nodular infiltrates c cylindrical bronchiectasis
Rheumatoid Nodule
Has active seropositive rheumatoid arthritis
- mutiple bilateral lung nodules
- subpleural necrotizing granuloma
Acute Respiratory Distress Syndrome (ARDS)
- aka Diffuse alveolar damage (DAD) or acute lung injury (ALI)
Defined as: pO2 / FiO2 < 300
- dec FRC; inc A-a gradient from R-L shunt; dec compliance b/c dec surfactant prod; dec O2 and dec CO2; NORMAL PCWP (essential for dx!!! [distinguish from cardiogenic causes])
~ may be caused by trauma, sepsis, shock, gastric aspiration, uremia, acute pancreatitis, amniotic fluid embolism; stuff that will cause the release of inflam cytokines
- neutros kill type I and II pneumocytes --> loss of surfactant --> ATELECTASIS (shunt [V/Q --> 0])
~ Diffuse alveolar damage --> inc alveolar capillary permeability --> protein - rich leakage into alveoli
- initial damage due to neutro substance release which is toxic to the alveolar wall, activation of coagulation cascade or O2 derived free radicals
- damage to endothelial cells lining pulmonary capillary (NOT to alveolar wall???)
2 phases: acute (exudative) and organizing (proliferative)
1) Early phase: congestion, bleeding, edema, lots of fibrin and hyaline membranes, type II pneumocyte prolif
2) Late phase: after 1 week, organization, fibrosis, type II pneumocyte hyperplasia
Micro: alveoli coated c amorphous pink hyaline membrane material and inc intraalveolar macrophages (seen during proliferative and exudative phases)
- multiple fibroblastic foci (occurs later than the above)
- may see fibrin thrombi in small vessels
Tx: Fix underlying cause!! Abx ONLY if bug found; sup O2 + PEEP w/ low VT

ARDS

ARDS
Neonatal respiratory distress syndrome (Hyaline membrane dz)
Surfactant deficiency leading to inc surface tension resulting in alveolar collapse
- Lecithin-to-Sphingomyelin ratio usually < 1.5
- surfactant made by type II pneumocytes most abundantly after 35th week
Risk factors: prematurity, maternal diabetes (inc insulin inhibits surfactant synth), C-section delivery (due to dec release of corticosteroids)
Tx: maternal roids before birth; artificial surfactant for infant; thyroxine
~ supplemental O2 may result in retinopathy
- roids have NO benefit after 34th wk
Px: if baby survives the 1st 4 days of life, has an excellent prog.
Pulmonary hypertension
Normal Pulmonary artery pressure: 10-14 mmHg;
in pulmonary hypertension: >= 25 mmHg; > 35 mmHg during exercise
- hear a loud P2
A dx of exclusion
- 50% present with exertional syncope
- PFTs will suggest a restrictive dz
Primary (familial): caused by an inactivating mutation in the Bone Morphogenic Protein Receptor 2 (BMPR2) gene (which codes for the TGF-B receptor superfamily and normally inhibits smooth muscle proliferation
- thus in primary (and in secondary) in the pulmonary arteries will see atherosclerosis, medial hypertrophy, and intimal fibrosis; will also see coronary sinus dilation
- primary MC in women, avg age: 36
- poor prognosis
Secondary: Due to COPD (destruction of lung parenchyma), mitral stenosis (inc resistance --> inc pressure), recurrent thromboemboli (dec cross-sectional area of pulmonary vasc bed); autoimmune dz (eg systemic sclerosis, CREST, SLE, MCTD; inflam --> intimal fibrosis --> medial hypertrophy); L-->R shunt (inc shear stress --> endothelial injury and inc pulmonary blood flow); sleep apnea or living at high altitude (hypoxic vasoconstriction [inc pulmonary resistance]); L heart resistance to blood flow also a cause (eg LV failure); idiopathic: rarely, only after r/o all other causes
Remember: Pulmonary artery pressure = (PVR x CO) + LAP
- LAP estimated by PCWP
in Right Ventricular Hypertrophy look for a parasternal lift
Progresses from Severe resp distress to cyanosis and RVHF to DEATH from decompensated cor pulmonale (manifests as congestive hepatomegaly ("nutmeg" liver), JVD, lower ext edema w hypoxia
- may treat with warfarin bc of inactivity due to sx and venous stasis (inc risk DVT?); also may consider lung transplant
Dx: CXR (R heart enlarged), EKG (RAD, peaked P waves, RVH), Swann-Ganz (most accurate/precise/invasive)
Tx: Underlying cause. O2 for hypoxemia (slows progression, esp in COPD). digoxin with LV failure. Vasodilators (sildenafil), iloprost, bosentan
- AVOID DIURETICS!! Pt may be preload dependent and vol reduction may cause heart failure! -
Spontaneous pneumothorax
Primary: Tall, young males with asymptomatic blebs or bullae
Secondary: Pts with underlying lung pathology (MCC COPD)
Dx: CXR
Tx: Chest tube drainage
Tension pneumothorax
One way valve in frontal/ visceral pleura --> inc pressure --> compresses SVC --> dec venous return and distended jugulars --> hemodynamic compromise
- trachea deviates away from side with inc pressure
Dx: Clinical. Just slam the needle in the lungs right away (immediate needle thoracotomy), no CXR needed
Atelectasis
Collapse of lung tissue.
First cause of fever postop (Wind, Water, Wound ...)
Discoid atelectasis: loss of lung vol from obstruction in lower lung (caused by bronchitis and pneumonia)
- may appear rounded if caused py fibrosis bwt pleura
Resorption (occlusion) atelectasis: airway obstructed by object --> airway collapse (dec lung sounds on PE)
Compression atelectasis: space occupying object in pleural cavity --> inc pressure on small airways --> collapse
~ may also be caused by dec surfactant (eg ARDS, hyaline membrane dz)
MCC; inadequate respiration; how to prevent this? --> Incentive spirometry!!! (Suck it, dont blow it... the spirometry thing! )
Dx: CXR
Plexiform arteriopathy
Result from vascular wall lesions
No assoc c cigarettes
Mutated BMPR2 in familial cases
Congenital Cystic Adenomatoid Malformation (CCAM)
- aka Congenital Pulmonary Airway Malformation (CPAM; bc not all lesions cystic / adenomatoid)
Occurs equally bwt right and left lungs, and has features of immaturity and malformation of distal lung parenchyma and small airways
- usually communicate c normal tracheobronchial tree
- assoc c stillbirth, neonatal distress, bronchial atresia, and frequently hydrops
- labs can show inc aFP
Divided into 5 categories based on site of origin, from 0-4:
MC subtype is Type I: has large cysts (10 cm max) lined by a "ruffled" ciliated columnar or pseudostratified ciliated cells c interspersed mucogenic cells, broad fibrous septa, no cartilage (in 90%), no sk muscle
- type I can have lepidic growth pattern into normal adjacent lung, making it look like carcinoma
-type 3 is almost always in males and is spongy without large cysts
DDx: Bonchogenic cyst
CCAM

Cystic fibrosis
AR, 1/20 white people are carriers, present in 1/2500 births in US
- mutations if CFTR cause reduced chloride ion in secretions and thicker respiratory secretions
- associated with allergic bronchopulmonary aspergillosis (ABPA), Burholderia cepacia, Hemophilus influenza, mycobacteria (atypical), Pseudomonas aeruginosa, Stenotrophomonus maltophilia
Gross: emphysema, bronchiectasis, abscess, fibrosis
Microscopic:
Bronchogenic Cyst
Midline, seen in the middle mediastinum; usually seen as a neck lesion in kiddos
Ciliated pseudostratified columnar epithelium
goblet cells (white globs in cells)
- can have circumferential sm m around cyst
- can have cartilage
- alveolar tissue is NEVER present
- No lymphoid follicles (vs branchial cleft cyst)
DDx: CCAM / CPAM, esophageal duplication cyst (both can be lined by ciliated columnar cells)
Bronchogenic Cyst

Minute Meningothelial-like Nodule
- aka chemodectoma-like body,
IHC: (+) EMA, PR
- neg: NE markers, CK
DDx: carcinoid tumorlet (SYN,CHR, CD56 +, and PR neg)

Minute meningothelial-like nodule
Idiopathic Pulmonary Hemosiderosis (IPH)
Assoc c large numbers of hemosiderin-laden macrophages in BAL specimens
- eosinophilia and iron-deficiency anemia seen
-- renal function usually normal
- not assoc c immunologic dz

IPH



Reactive Pneumocytes
Reactive changes can be esp severe in florid DAD, where hyaline membranes assoc c markedly atypical pneumocytes
Micro: usually have a spectrum of atypia in reactive conditions
- reactive pneumocytes also have cytoplasmic vacuolization of frequent binucleation
- NC ratios are preserved in reactive conditions despite larger nuclei
- "Napoleon hat" sign is also seen in reactive cells that seem to have pinched off edges of the nuclei (corresponding to where pneumocytes are plastered against the alveolar wall)
in acute/subacute lung injury can see marked cytomegaly, prominent nucleoli, and chromatin irregularities
- giant macronucleoli (similar to melanoma) can be seen
- nuclear contours can be focally irregular, but usually remain smooth
Literature shows many examples of reactive pneumocytes called malignant, esp in ARDS pts in cytology specimens or in granulomatous inflammation
Reactive pneumocytes showing "Napoleon's hat" sign with pinched off nuclei (Rekhtman N, "Napoleon Hat" sign: a distintive cytologic clue to reactive pneumocytes. Arch Pathol Lab Med Vol 144 April 2020)

Lung Neoplastic
Epithelial Tumors
MCC of cancer DEATH
- smoking accounts for 85% of cases, and there is a linear relationship bwt pack years and lung ca risk
~ radon also inc ca risk
Cytology may be good for Central tumors, but is not very specific
On the other hand, transthoracic bx. is highly accurate; always performed in thoracic lymphadenopathy in confirmed cancers
S/Sx: cough, hemoptysis, bronchial obstruction, wheezing, pneumonic "coin" lesion on CXR (although CXR is highly sensitive, there is NO ROUTINE Screening)
Complications: SVC syndrome, Pancoast's tumor, Horner's syndrome, Endocrine (paraneoplastic), Recurrent laryngeal symptoms (hoarseness), Effusions (pleural or pericardial - always tap it and review the cytology)
Mets to lung (MC) - from prostate, bladder, breast, colon (? where exactly, and where MC? - use citation)
Adenocarcinoma
EVEN FOCAL POSITIVITY FOR TTF1 is SUFFICIENT to FAVOR ADENOCARCINOMA (at least according to CAP PIP-A 2023)
- clone 8G7G3/1 of TTF1 is more specific, while SPT24 is more sensitive
2015 Classification:
Pre-Invasive Lesions
- Atypical Adenomatous Hyperplasia (AAH)
- AC in Situ (AIS)
--- can be mucinous, non-mucinous and mixed
Minimally Invasive Ac (MIA)
--- can be mucinous, non-mucinous and mixed
Invasive Ac
- lepidic, acinar, papillary, micropapillary, or solid
Variants of Invasive Ac
- Invasive Mucnous Ac
- Colloid
- Fetal
- Enteric
Note: Broncho-alveolar carcinoma (BAC) does not exist anymore
MCC (38%) lung ca, young non-/light-smokers
- is an "oddball" b/c grows slowly and mets early; also has usually (~8/10) have invaded visceral pleura at excision
- MC subtype (80%) is mixed (numerous subtypes), though papillary adenoca also very popular
- percentages of each subtype should be included in final report, not bc they are distinct entities (they are part of a spectrum), but bc they may have prognostic significance; also important for identifying intrapulmonary mets of a primary lung adenoca, which tend to change histo patterns
Atypical adenomatous hyplerplasia (AAH) if <5mm,
called AIS if >5mm up to 3 cm
Clear cell, rhabdoid, and signet ring are not specific subtypes, but rather just features that are worth mentioning in report for comparing multiple lung adenocas
Genes: KRAS, TP53 [4], EGFR (esp in non-smoking East-Asians [4]), and ALK mutations (see below for discussion)
- EGFR and ALK mutations have assoc tx
IHC: (+) thyroid transcription factor 1 (TTF-1, ~80%), CK7, EMA, CEA, MUCs (MOC1), napsin A, Ber-EP4
- negative: CK20, CDX2 (to differentiate from colon mets though positive in mucinous variants) [4]
peripheral location
Clara cells get transformed to type II pneumocytes, which may explain inc mucin production, and may be related to inc spread (along alveolar walls [?])
Tx: gefitinib (c EGFR mutation [an RTK small molecular inhibitor]) [2]
Px: small focus of invasion <5 mm has NO impact on survival
Minimally Invasive Adenocarcinoma (MIA)
Small (<3 cm) and solitary c predominantly lepidic growth, the invasive ca <0.5 cm in any focus, and includes any invasive architectural pattern (acinar, papillary, solid, colloid etc) or cells invading the myofibroblastic stroma
- MIA excluded if tumors has necrosis, spreads through air spaces, "lepidic" growth pattern, or invades lymph, BV, air spaces or pleura
- cells mostly nonmucinous (type II pneumocytes [Clara cells]) though can have rare mucinous cells (columnar cells c mucin), no nuclear atypia, commonly see sclerosis/elastosis c septal widening
Since the entire tumor needs to be embedded to dx MIA or AIS, dx on a bx should just be "adenoca c lepidic pattern" c a comment
Imaging: pure ground glass appearance
Invasive mucinous adenocarcinoma
- formerly known as mucinous bronchoalveolar carcinoma (BAC), but renamed in the new classification
- multiple nodules, >3 cm
Has major clinical, radiologic, pathologic and genetic differences from the tumors formerly called nonmucinous BAC
- in particular, has a very strong correlation c KRAS mutation, whereas nonmucinous AC likely have EGFR mutations
- in majority of cases has an invasive component, and tend to be multifocal
IHC: (+) CDX-2 (sometimes(
- neg: TTF-1 (0-17% pos in studies)
Px: Not good, commonly recurs after resection
Bronchioloalveolar Carcinoma (BAC)
*** TERM NO LONGER USED*** (now "lepidic" used for non-invasive part of an invasive adenoca
May look like pneumonia on PE, and may cause hypertrophic osteoarthropathy (get some pain in the long bones)
- direct precursor to metastatic carcinoma
- lepidic crawl often seen at tumor periphery in alveolar septae
Mucinous Adenocarcinoma
spread via airways (lepidic) and have satellite lesions
- has KRAS mutation (?)
Imaging: Appears solid on CT, may resemble lobar pneumonia if entire lung consolidated
Invasive mucinous adenoca is what used to be called mucinous BAC
IHC: (+) CK7/20 (var), possibly CDX2 (focally), PAS (resistant to diastase), CD15, BerEP4, mCEA
- neg: TTF-1 (1/5+), Napsin A (var), p63 (var), CK903/5/6 (var), NE markers
Nonmucinous Adenocarcinoma
IHC: (+) TTF-1 (~9/10), NapsinA, CK7,PAS (resistant to diastase), CD15, BerEP4, mCEA
- neg: CK20, p63 (var), CK903/5/6 (var), NE markers
Tx: less likely to be cured with excision
Genetics for Lung Carcinoma [3]
In general, genetic mutations are mutually exclusive (only get a mutation along one pathway), KRAS mutations are the result of many mutations and are seen with smokers (get lots of mutations over time) which is treated with generic chemo
- more specific mutations (EGFR, ALK) can be treated with specific therapies
Order of frequency in NSCLC: EGFR (40%) > KRAS > ALK
- c-kit and BRAF mutations do not play important role in management
Epidermal Growth Factor Receptor gene (EGFR) mutation
MC affect exons 18-21 (esp arg to leu switch at aa858 in exon 21 and in-frame deletions in exon 19), encoding a portion of the tyrosine kinase domain, FISH better than IHC
- MC in young Asian females and/or never smokers
- tumors c mutations in exons 18-21 respond to EGFR-TKIs but are unlikely to respond to anti-EGFR monoclonal abs
- secondary resistance assoc c certain additional mutations in EGFR (T790M) as well as mutations in other genes such as MET
- gefitinib is an antagonist of EGFR-TK, pts c L858R mutation in EGFR are potential candidates to get targeted tx c gefitinib
METex14 mutations abolish binding site of E3 ubiquitin-protein ligase BCL that interacts c MET via residue Y1003 in exon 14 of MET
- causes dec ubiquitination and relative inc of MET protein levels and enhanced MET oncogenic activity
- METex14 alterations occur in 2-3% of ung cancers by 2 mechs:
1. mutations of METex14 splice sites resulting in METex14 skipping and MET Y1003 mutaions
- METex14 deletion causes inc MET protein expression levels, enhanced MET phosphorylation, prolonged MET activation in lung cancer
- METex14 alterations seen in older pts c NSCLC and are enriched in sarcomatoid histologies
- MET co-amplification seen in up to 21% of METex14+ NSCLC, and Crizotinib has clincal activity in NSCLC c MET amplification esp in pts c high MET amplification
Structurally similar to ERBB2 (HER2/neu)
- ERBB2 amplification occurs in up to 15% of relapses after TKI tx (may help to use HER2/neu inhibitors
Controls cell growth
Gefitinib and erlotinib (Tyrosine-kinase inhibitors) may help only subset of pts (non-smoking Asian females) with somatic gain-of-function mutation in tyrosine kinase genes
- 90% of EGFR mutations are in LREA (Leu Arg Glu Ala, E746-A750 del) of exon 19 or missense point mutation in p.Leu858Arg (L858R) in exon 21
-- EGFRs can independently activate, but this fortuitously allows stabilization bwt TKIs and the kinase (??)
- EGFR mutations also assoc c adenosquamous, large cell and rarely SC carcinoma; but having EGFR mutation almost guarantees ACA morphology
- high-level amplification of EGFR correlates c better response to TKI tx
- most pts have ACA relapse after ~1yr TKI tx MC (60%) due to T790M substitution in EGFR exon 20, which leads to resistance
-- up to 20% have MET amplification after TKI tx (gene involved in organ growth, esp hepatocytes), possibly due to cell selection (MET amplified cancer cells there from beginning and get selected by tx);
---can occur c T790M
Kirsten rat sarcoma 2 viral oncogene homolog (KRAS) mutations
Highest KRAS mutation rate in mucinous AC
MC mutated driver oncogene in ACA (?)
- is downstream of EGFR
90% of KRAS mutations are single-nucleotide missense mutations in codons 13-14 and 61
More asoc c smoking and is the MC somatic oncogenic mutation in NSCLC in white non-Hispanic pts
Mutually exclusive (does not occur c other gene mutations [ALK, EGFR])
Combo selumetinib / docetaxel tx may be helpful, but has significant side effects
- currently are testing MEK inhibitors in these pts
Anaplastic Lymphoma Kinase (ALK)
EML4-ALK translocation fusion gene of the transcription activation domain of ALK c the dimerization domain of EML4, leading to constitutive activation
- results from interstitial inverstion in the short arm of cr 2 (inversion of 2p)
5% of adenoca's have EML4-ALK translocation on cr 2, giving the tumor a cribriform mucinous and signet ring pattern
- detected c FISH break-apart (may be difficult to interpret 2/2 subtle paracentric inversions) or by IHC
- TX: Crizotinib (originally designed for Met translocations) has ~60% response rate
--- pts usually relapse after 1 year of crizotinib
BRAF mutations (50% of which are V600E [like hairy cell leukemia and melanoma and gastric ACA])in 4% of lung ACAs
ROS and RET mutations seen in 1% of ACA
-ROS mutations may be mutually exclusive, like KRAS
- RET MC in pts c hx of rads
Half of lung ACA are unclassified ("pan-wild" or non-oncogene type), which are MC in never / light smokers
Rads: See multiple densities on CXR
Tx: Crizotinib for adenoca c translocations
ROS1 mutations
Similar to ALK mutations, may respond to tyrosine kinase inhibitor therapy (crizotinib)
- accounts for 1-2% of pulmonary AC
Programmed Death Receptor-1 (PD-1)
Immunoregulatory receptor expressed by activated T cells, and its ligand, PD-L1 in cancer cells have been promising targets
Lepidic adenocarcinoma
Non-invasive part of an invasive adenoca, though should be mostly lepidic
- should estimate the percentage of invasive component and the size of the invasive (which can be estimated based off the % invasive component multiplied by the greatest tumor dimension)
-- vs MIA, lepidic pattern has invasive component >0.5 cm
- Spread Through Air Spaces (STAS) is tumor cells beyond tumor in air spaces in surrounding lung parenchyma and should be included in the % of the invasive component calculation
-- can correlate c CT to see size of invasive part
- tumors > 3 cm c invasive component < 0.5 cm can be called "lepidic adenoca, suspect AIS or MIA"
Even if papillae surrounded by lepidic pattern, call it micropapillary (see image)
Imaging: ground glass nodule c a solid component >0.5 cm
Px: excellent in stage I dz
Acinar adenocarcinoma
Papillary adenocarcinoma
Micropapillary adenocarcinoma
Even if papillae surrounded by lepidic pattern, call it micropapillary
Cytologic atypia can be mild and doesnt correlate with px
Genes: EGFR mutations reported in this variant
Px: poor, likely to recur after limited resection
- improved response to adjuvant chemo
Solid adenocarcinoma
Even if mucin is absent, expression of TTF-1 and/or Napsin-A good for separating it from SCC
- solid adenoca is what was formerly known as a large cell ca with pneumocyte marker expression (TTF-1, Napsin-A)
- should have at least 2 HPFs c 5+ cells c intracellular mucin (though not req'd???)
Px: poor
- improved response to adjuvant chemo
Colloid adenocarcinoma
Includes what used to be mucinous cystadenoca
Fetal adenocarcinoma
well-differentiated fetal adenoca assoc c B-catenin mutations
Enteric adenocarcinoma

Atypical Adenomatous Hyperplasia (AAH)


Invasive mucinous AC (formerly mucinous BAC)


Poorly differentiated adenocarcinoma of the lung. The needle core biopsy shows a solid pattern of malignant large cells without glandular formation (A). The tumor cells are positive for thyroid transcription factor 1 (B) and napsin A (C). The tumor cells are negative for both p40 (D) and cytokeratin 5/6 (E) (hematoxylin-eosin, original magnification3400 [A]; original magnification3400 [B through E]).

[7]

Figure 3. Moderately differentiated adenocarcinoma of the lung. The biopsy shows a moderately differentiated adenocarcinoma with an acinar pattern (hematoxylin-eosin, A). The tumor cells express the EGFR mutant protein, E746-A750 (B)(hematoxylin-eosin, original magnification x200 [A]; original magnification x200 [B]).
Figure 4. Poorly differentiated adenocarcinoma of the lung. The biopsy shows poorly differentiated adenocarcinoma with a solid pattern (A). The tumor cells express the EGFR mutant protein L858R (B) (hematoxylin-eosin, original magnification3200 [A]; original magnification3200 [B]).

Figure 5. Moderately differentiated adenocarcinoma of the lung. The biopsy shows a moderately differentiated adenocarcinoma with an acinar pattern (A). The tumor cells express ALK protein (B) (hematoxylin-eosin, original magnification x200 [A]; original magnification x200 [B]).
Figure 6. Poorly differentiated adenocarcinoma of the lung. The biopsy shows a poorly differentiated adenocarcinoma with acinar and micropapillary patterns (A). The tumor cells express ROS1 protein (B) (hematoxylin-eosin, original magnification3200 [A]; original magnification x200 [B]).

Micropapillary adenoca (arrows; surrounded by lepidic growth) [5]

Spread Through Air Spaces (STAS) beyond edge of primary tumor
Micropapillary adenocarcinoma


Squamous cell carcinoma
EVEN FOCAL POSITIVITY FOR TTF1 is SUFFICIENT to FAVOR ADENOCARCINOMA (at least according to CAP PIP-A 2023)
MCC (~1/3) of lung cancer death
Squamous, Sentral, Smoking
- asbestos has synergistic effect on oncogenesis with smoking
- called Pancoast's tumor when arising in the superior sulcus (groove formed by the subclavian vessels in the apex of the lung) assoc c Horner's syndrome (Ptosis, Anhidrosis, Miosis [PAM is Horny!])
- includes the basaloid subtype, which was formerly part of large cell ca
Imaging: Usually a hilar mass arising from bronchus
looks like a Cavitating lesion on CXR, causes an obstructing pneumonia
Labs: assoc w hyperCalcemia of malignancy
- produces PTHrP
Micro: keratin pearls and intercellular bridges on histology
IHC: diffuse positive nuclear p63/40, CK5/6 (var), napisin (p40 superior to p63 to confirm the dx)
(-) TTF-1 (but, SPT24 clone more likely to be positive than 8G7G1), Napsin A, CK7 (var), CK20, NE stains
-- good panel is TTF-1, p63 and CK5/6
- still dx SCC if morphology not present but it's still supported by stains
Genes: 3p del, p53, K-ras, p16 mutations
Tx: Nivolumab (a programmed death-ligand [PDL] ab) given for advanced dz [5]
- bevacizumab contraindicated in SCC 2/2 risk of pulmonary hemorrhage
Px: no difference bwt keratinizing and nonkeratinizing; basaloid may be worse, not sure

Poorly differentiated squamous cell carcinoma of the lung. The needle core biopsy shows sheets of malignant large cells without obvious squamous differentiation (A). The tumor cells are positive for p40 (B) and cytokeratin 5/6 (C). The tumor cells are negative for both thyroid
transcription factor 1 (D) and napsin A (E) (hematoxylin-eosin, original magnification x400 [A]; original magnification x400 [B through E]).
[7]

[7]
A major pitfall in interpreting IHC-stained slides of small
lung biopsy samples is the positivity of normal alveolar
epithelium for TTF-1 and/or napsin A.

[7]



Diagn Cytopathol 2013; 41

WHO Tumors of Lung, 2015
Neuroendocrine Ca's
Small cell lung ca- SCLC
10-15% of lung ca's; MC NE ca
All are high grade (>11 mits per 10 hpf, highly malignant, widely metastatic, very aggressive, undifferentiated) - basically a high grade version of carcinoid
- see extensive pulmonary necrosis
- MCC SVC syndrome
- dont use term "oat cell ca" anymo
- Presents CENTRALLY with circumferential infiltration beneath the bronchial mucosa; rarely presents as an exophytic endobronchial lesion (which is usually seen c bronchial carcinoids)
May produce: ectopic ACTH / ADH; may cause Lambert-Eaton syndrome (autoabs against Ca2+ channels)
Sentral location
Histo: neuroendocrine Kulchitsky cells (small dark blue cell tumor) in sheets, salt n peppa chromatin c no nucleoli; crushed, high NC, nuclear molding, scant cytoplasm
- lots of necrosis and mits
IHC: (+) neuron-specific enolase, chromogranin, synaptophysin, CD57, TTF-1 (9/10), Cam5.2 and AE1/AE3 (punctate positivity)
- differentiated from carcinoids with a high mitotic rate (>20%, usually ~70%)***
- neg: Napsin A, CK7 (var), CK20, p63, CK903/5/6
- don't need stains to dx small cell ca (1/10 small cell ca's neg for all IHC; do need IHC for large cell dx)
Anti-apoptotic BCL-2 in 90%; L-MYC oncogene
Tx: Inoperable but responsive to chemo
Px: poor; usually met'd at time of discovery
- mean survival after dx: 1 year
Large cell carcinoma
5-10% of all lung ca., dx of exclusion, can only be dx'd on resection specimens (not bx or cytology)
Subtypes: large cell neuroendocrine ca, basaloid ca, clear cell ca, lymphoepithelioma-like ca
- peripheral (except basaloid subtype)
- mix of squamous and adenocarcinoma (?)
Highly anaplastic undifferentiated tumor
- pleomorphic giant cells with leukocyte fragments in cyoplasm
Makes B-hCG (?)
Px: Poor; not very responsive to chemo - removed surgically
Important variant: Large cell neuroendocrine carcinoma (trabecular or palisading)
Large cell NeuroEndocrine carcinoma (LCNEC)
Aggressive [high grade, >10 mits / 10 hpfs], ca of large malig cells c NE appearance (organioid nesting, palisading, rosettes, trabeculae), c lots of mits and necrosis
- 65 yo male smoker
- can look like NSCC, but on closer look has NE features that are confirmed c special stains
- peripheral
Micro: tumors cells larger than those in atypical carcinoid c lots o cytoplasm, big nulceoli (vs absent in small cell ca), high nuclear grade, lots of mits (>=10) and lots of necrosis
- growth patterns: organoid/nesting, trabecular, palisading, rosettes
Cytology: nuclear palisading and molding, rosettes; lots of mits and necrosis
IHC: (+) NE markers (synaptophysin, chromogranin, CD56), CD117 (60%), TTF1 (50%), GLUT1 (74%), Ki67 (>20%, usually 50%+), Phosphohistone H3 (for highlighting mits)
- neg Napsin, S100 (+ in sustentacular cells)
Px: Poor, even c stage I dz
(Bronchial) Carcinoid tumor
Gross: elevated hyperemic mucosal nodule
- 5% of all lung tumors, in 40 yo non-smokers
- 55-85% 5-year survival rate if atypical, 95% if typical (vs 30% large cell, 5% small cell) - much better than other NE tumors
- usually central, but peripheral tumors solid and nodular (round); often discovered incidentally on imaging, though can cause sx of obstruction
- gray cut surface that occludes main stem bronchus
Carcinoid <5 mm = a carcinoid tumorlet, not carcinoid (unless there is a met, then can call the <5mm lesion carcinoid...)
- seen in pts c bronchiectasis and intralobar sequestration
Can be typical or atypical; differentiate from other pulmonary neuroendocrine ca's (LCNEC and small cell ca) c mitotic rate
- typical carcinoid has LOW MITOTIC INDEX (up to 15%, or 2 mits/10 hpf [2 mm]) and lacks necrosis
- atypical: 2-10 mits/10 hpfs
- Large Cell NE Ca (LCNEC): >10 mits/10hpfs
-- should count mits in a 2 mm2 area; cutoffs being 2 or 20 mits; if close to cutoffs count three 2 mm2 areas and take the avg (count in area c highest # mits)
-- both typical and atypical can have nuclear atypia and pleomorphism ( cant use those feature to predict malignancy)
Micro: Small blue cell tumor with sheets and nests
- more spindle cells seen if found at periphery
- growth patterns - organoid, tabecular, insular, palisading, ribbon, rosette, spindly, papillary, pseudoglandular, follcular
- oncocytic features common
- looks like carcinoid of GI
Low grade malignancy (?)
Collar-button lesion: breaks through bronchial wall and invades peribronchial tissue
- Round "button-like" masses that project into the lumen of the bronchus (usually mainstem)
Classified as typical or atypical
- depends on mits and necrosis (see IHC)
Genes: few abnormalities (compared to SCLC / LCNEC)
EM: dense core membrane-bound neurosecretory granules
Secretes serotonin and histamine (derived from Kulchitsky [NE] cells) and thus may produce carcinoid syndrome (though most do NOT present w classic carcinoid syndrome [wheezing, flushing, diarrhea, salivation, R heart failure], but rather with cough, hemoptysis, pneumonia, emphysema, and bronchiectasis from bronchial lumen obstruction
- occurs in 10% of bronchial carcinoids
IHC
(+) TTF-1 (1/2), SYN, CHR, CD99/56
(-) S100, Napsin A, CK7/20, CK903/5/6, HMB45, smooth muscle actin, desmin, p63
- typical carcinoid has <2% Ki67 positivity, whereas atypical carcinoid has <20% (usually ~10%)
Tx: most do not met (10-15%) --> resectable
Assoc c MEN I
Px: metastatic potential (even if they look b9 cytologically)
- better px features are pseudoglandular growth pattern, papillary growth pattern or palisading
Adenosquamous carcinoma
Sarcomatoid carcinomas
Best to dx specific subtype rather than the general "sarcomatoid ca" to avoid confusion c sarcoma
- sarcomatoid ca's are rare (<1% of all lung ca's)
- can't dx pleomorphic, spindle cell or giant cell ca and is very difficult to dx carcinosarc or pulmonary blastoma on bx or cyto
Px is poor for all these tumors
Pleomorphic Ca
Poorly differentiated NSCC c at least 10% spindle and/or giant cells
Spindle cell Ca
Almost pure population of epithelial spindle cells c no differentiated carcinomatous elements
Giant cell Ca
Almost entirely made of giant cells / MNGCs with no differentiated carcinomatous elements
Carcinosarcoma
Mix of SCC/adenoca and sarcoma (rhabdomyosarcoma, chondrosarcoma, osteosarcoma)
- clonal tumors that develop from sarcomatoid change in a carcinoma
Genes: usually has TP53 mutations
- less common are KRAS and EGFR muations
Pulmonary blastoma
Biphasic tumor c (low grade) fetal adenocarcinoma and primitive mesenchymal stroma
- may have sarcomatous elements, but not necessary to dx
Genes: CTNNB1 exon 3 missense mutation which activates Wnt pathway by B-catenin aberrant nuclear/cytoplasmic localization
- this is also seen in well-differentiated fetal adenoca
- may also see TP53 mutation c p53 and MDM2 protein accumulation
Lymphoepithelioma-like ca
NUT carcinoma
A poorly-differentiated subset of SCC with a rearrangement in the NUclear protein of Testes (NUT) gene; vast age range; M=F
- usually a translocation bet NUTM1 on cr 15q14 and other genes, usually BRD4 on cr 19p13.1 in 70%
Micro: Sheets and nests of small- to intermediate undifferentiated cells c monomorphic look
- irreg nuclear contours c granular / course chromatin
- usually see areas c keratinization
IHC: (+) NUT ab, appears speckled in nuclei
Px: very aggressive; survival ~ 7 mo
- usually advanced stage at dx
Salivary gland-type tumors

Small cell lung carcinoma. The biopsy shows a sheet of small round hyperchromatic cells with peripheral crush artifact at low power (A). At high power, the biopsy shows small round cells with scant cytoplasm, even and finely granular chromatin, inconspicuous nucleoli, and high mitotic activity (B). The tumor cells are positive for cytokeratin 7 (C), synaptophysin (D), and thyroid transcription factor 1 (E). The Ki67 proliferative index is greater than 90% of the tumor cells (F) (hematoxylin-eosin, original magnifications x40 [A] and x400 [B]; original magnifications x400 [D] and x100 [C, E, and F]). [7]
LCNEC

LCNEC

Pulmonary Neuroendocrine Tumors`

Typical carcinoid partially obstructing the lumen

Carcinoid tumorlet (<5 mm)

Bronchial carcinoid

Carcinoid

Atypical carcinoid




Pleomorphic carcinoma with prominent spindle cell component of the lung. The biopsy shows a proliferation of malignant spindle cells (A), with tumor cells positive for thyroid transcription factor 1 (B). The tumor cells are strongly positive for programmed death receptor-1 (C) (hematoxylin-eosin, original magnification x200 [A];
original magnification x200 [B and C]).

NUT carcinoma
Papillomas
Squamous cell
- similar features to other non-pulmonary sites
- may show dysplasia, be be careful because lots of reactive changes usually present
- lack columnar-type epithelium
Glandular (adenoid)
- uncommon, endobronchial-based proliferations, typically in the proximal airway, M=F
Micro: papillomatous neoplasm with broad fibrovascular cores that are fibrotic and hyalinized
- goblet cells admixed throughout the epithelium
- no evidence of stromal invasion
- mits and necrosis not seen
Px: Benign with low risk of recurrence
Mixed (transitional, Schneiderian)
glandular papilloma, with stromal fibrosis

glandular papilloma with glandular and squamous-type epithelium

Adenomas
Sclerosing pneumocytoma
- previously known as sclerosing hemangioma (changed in 2015, bc are not vascular in origin)
Rare, derived from primitive respiratory epithelial cells (type 2 pneumocytes) that express TTF-1
- 5F > 1M
Gross: solitary nodule / mass that is well-defined, oval, homogeneous
Micro: Two cell types seen-- round stromal cells and cuboidal surface cells that look like type II pneumocytes
- often have multiple growth patterns (solid, sclerosing, papillary, etc)
IHC: (+) TTF-1 and EMA (in both round and surface cells), napsin A, CK only in surface cells
- neg: CD34, CD31
Px: typically B9

Sclerosing pneumocytoma. The biopsy shows a low-grade epithelial neoplasm (A) positive for AE1/AE3 (focal) (B), Cam5.2 (C), and thyroid transcription factor 1 (D) and negative for cytokeratin 7 (E) (hematoxylin-eosin, original magnification x400 [A]; original magnification x400 [B through E]).


Alveolar adenoma
Uncommon, usually an incidental finding
Micro: well-circumscribed, low columnar to cuboidal hobnailed cells lining cystic spaces
- cystic spaces usually larger near the center of the lesion
- intervening cells in stroma usually bland spindly to epithelial cells, can be in myxoid collagenous background
IHC: TTF-1 positivity in hobnailed cells
- stromal cells are TTF-1 negative
DDx: sclerosing hemangioma (TTF-1 positivity in both stromal and epithelial lining cells)
Alveolar adenoma

Papillary adenoma
Single defined mass - rare (only a few have been reported), usually occur in periphery of lung, but may arise centrally
Micro: papillary prolif c fibrovascular cores lined by single layer of cuboidal non-ciliated epithelial cells that resemble type II pneumocytes
- no necrosis or significant cytologic atypia
IHC: (+) CK, CK7, TTF-1, napsin A, p63, b-catenin, surfactant apoprotein A
Tx: conservative surgical removal
Px: previously considered b9, but bc of infiltrative growth pattern may be considered an intermediate lesion
Mucinous cystadenoma
Make sure its not a met in a female
Mucous gland adenoma
Derived from mucoserous glands of bronchial lining
Papillary adenoma

Mesenchymal Tumors
Hamartoma
MCC benign lung tumor (75%), peripheral
- popcorn calcifications diagnostic
Micro: has at least two types of mesenchyme, usually c islands of hyaline cartilage (chondrocytes in lacunae) and normal looking connective tissues and fat cells; can also have bone and smooth muscle
DDx: carcinoid, small cell ca, adenoca
- Useful features to help differentiate a PH from a
chondroma are the presence of fibromyxoid tissue, adipose tissue, smooth muscle, entrapped epithelium, and the lack of calcification
Genes: t(3;12)(q27-28;q14-15) which fuses HMGA2 and LPP genes
IHC: usually not necessary to dx, but can highlight the different mesenchymal elements
Hamartoma


Pulmonary Chondroma
Usually presents as a part of Carney Triad (CT), a rare non-hereditary, multiple endocrine neoplasia tumor predisposition syndrome and part of SDH-deficient tumors
Well-circumscribed, purely cartilagenous tumor
- Adipose tissue, fibromyxoid tissue, smooth muscle, and entrapped respiratory epithelium are absent
- Mild cytologic atypia is often present; however, moderate and rarely even marked atypia may be found
- Foci of myxoid change, hyalinization, ossification with or without marrow elements, infarct like necrosis, and coarse calcification are additional features
DDx: hamartoma
- Useful features to help differentiate a PH from a
chondroma are the presence of fibromyxoid tissue, adipose tissue, smooth muscle, entrapped epithelium, and the lack of calcification
- In contrast to PC, PH have been found to
frequently harbor the translocation (3;12)(q27-q28;q14-q15), resulting in the fusion gene HMGA2::LPP

Chondroma
Epithelioid hemangioendothelioma
Low/int grade malig vascular tumor seen in women<50yo
- may also be in liver or bone
- 10% c peripheral eosinophilia
Multifocal c fibrotic, necrotic or sclerotic nodules of epithelial endothelial cells in myxohyaline stroma
- bland / round/oval nuclei, can see cytoplasmic vacuoles
- preserved lung architecture
IHC
(+) CD31, CD31/34, FLI1 (more sensitive) and Factor VIII (less sensitive); focal CK in ~25%
Genes: WWTR1 and CAMTA1 gene translocation
- may also have YAP1-TFE3 fusion
Px
Lower grade than angiosarcoma, but still has tendency to recur; 6/10 5 yr survival
- poor if vascular spread, pleural involvement, severe sx, lots of mits, necrosis or nuclear atypia
Epithelioid hemangioendothelioma

PEComatous tumors
Tumors that are derived from perivascular epithelioid cells
- includes benign and malignant PEComas (clear cell tumor), and lymphangioleiomyomatosis (LAM)
Lymphangioleiomyomatosis (LAM)
Low-grade destructive and metastasizing neoplasm seen in young women (childbearing years) assoc c Tuberous Sclerosis (TS)
-- clear cell "sugar" tumor is also in this category of tumor (PEComatous tumors) and has HMB+
Micro: Disorganized prolif of plump spindly myoid cells c reddish cytoplasm found in the walls of air spaces, but also possibly in BV/lymphatics (causing bleeding)
- thin-walled sinusoidal vessels
- mild nuclear atypia, no mits or necrosis
- air-filled cysts common 2/2 air-trapping from bronchiolar narrowing
IHC: (+) SMA, HMB45, melan A, B-catenin, micropthalmia transcription factor, sometimes ER/PR (+)
- has glycogen-rich cytoplasm which is removed c diastase digestion
- negative S-100
Genes: Express TSC2 (assoc c Tuberous Sclerosis in 3/20; part of PEComa group)
- causes abnormal signaling in MTOR pathway
LAM

PEComa
- aka Epithelioid myomelanocytoma or clear cell "sugar" tumor
In same groups as LAM (another PEComatous tumor)
IHC: (+) HMB45, CD117, possibly also muscle-specific actin, S-100, NSE, and MITF-1
DDx: Should r/o metastatic RCC (would be keratin +)
PEComa

Congenital peribronchial myofibroblastic tumor
Diffuse pulmonary lymphangiomatosis
Inflammatory myofibroblastic tumor (IMT)
Rare, myofibroblastic spindle cell neoplsm c characteristic fibroinflammatory and pseudosarcomatous appearance
- called inflammatory myofibroblastic tumor (IMT) if neoplastic and inflammatory pseudotumor if inflammatory
- may also be called pseudosarcoma, atypical myofibroblastic tumor, plasma cell granuloma (may be related to IgG4-diseases)
- seen in females, children and young adults
- grossly can be large, often gelatinous, polypoid mass
Micro: must be spindled myoepithelial cell proliferation c lymphocytic infiltrate
- patterns include: loose stellate cells c myxoid background c scattered inflam cells (nodular fasciitis-like); spindle cells c compact fascicular pattern (fibrohistiocytoma-like), sparse cellular, collagenous areas (desmoid-like) and mixed
- rarely see necrosis or hemorrhage
IHC: (+) SMA, desmin, ALK1 (up to 9/10), calponin
- neg: EMA, myogenin, p53, h-caldesmon
Genes: usually ALK+ or ALK gene rearrangements by FISH
IMT

Pleuropulmonary blastoma
See below in Pleura, neoplastic
Synovial sarcoma
Rare tumor in lung; assoc c chest pain, hemoptysis, dyspnea, cough and fever; rarely cystic
Micro: monophasic spindle cells or biphasic c epithelial and spindle cell component
- monophasic tumors c compact fascicles of hyperchromatic spindle cells c HPC-like areas, usually c small arteries and capillaries in irreg distribution
- poorly diff tumors can be small round blue cells tumors
- can rarely have rhabdoid features
IHC: (+) TLE1 (very specific)
- neg: CD117
Genes: t(X;18)(p11.2;icq11.2)
SYT-SSX2 fusion proteins c 89% 5-yr survival vs 42% in SYT-SSX1 fusion proteins
Synovial sarcoma (biphasic)

Pulmonary artery intimal sarcoma
Pulmonary myxoid sarcoma c EWSR1-CREB1 translocation
Malig tumor that always arises in airways usually in young adult females
Micro: cords of slightly atypical round / spindle cells in mucinous stroma c lobes of lacy stuff
- can have fibrous pseudocapsule
- mild cellular atypia
- usually low mits (though can be high) and 1/2 have necrotic areas
IHC: Vimentin (100%), EMA (60%)
- negative CK, S100, SMA, desmin, CD34
Genes: EWSR1-CREB1 fusion seen on FISH not completely speceific for this entity (also in clear cell sarcoma and angiomatoid fibrous histiocytoma) but the morphology helps to differentiate

Pulmonary myxoid sarcoma
Myoepithelial tumors
Rare in lung, can have spectrum of trabecular or reticular patterns usually c lots of mucin in the stroma, but do not show ductal differentiation (would be a mixed tumor)
Micro: uniorm nuclei c epithelioid/spindly cells c reddish to clear cytoplasm
- may see hyaline inclusions in cytoplasm or plasma cell- like cells
IHC: (+) S100, keratin, calponin, GFAP, possibly SMA and p63/40
- negative desmin, CD34
Genes: can have EWSR1 rearrangement [5]
t
Myoepithelioma
Myoepithelioma
Myoepithelial ca
Lymphohistiocytic tumors
Extranodal marginal zone lymphomas of mucosa-associated lymphoid tissue (MALT lymphoma)
asdf
Bronchial-Associated Lymphoid Tissue (BALT) Lymphoma
MCC lymphoma in the lung
- nodular prolif of small monotonous B lymphs
- is a low-grade tumor similar to MALT lymphoma
IHC:
- neg: CD10 / 56
Diffuse large cell lymphoma
Lymphomatoid granulomatosis
EBV-(+) T-cell rich lymphoma of B-cell origin c vasculocentric necrotic nodules in middle-aged pts that contain lymphoid infiltrate which can invade vessel walls and lift the endothelium
- despite name, does not have true granulomas
- may involve skin and CNS (4/5 have extrapulmonary manifestations)
Imaging: bilateral, well-defined mass densities that can give appearance of metastasis
Histo: lots of plasma cells, immunoblasts, large atypical lymphoid cells esp in walls of vessels and subendothelial space and occasionally in vascular space
Tx: complete remission c chemo in 50%
Px: worse c greater # of large atypical cells
Intravascular large B cell lymphoma
Pulmonary Langerhans cell histiocytosis
Assoc c young adult smokers; tx: stop smoking!!
Groups of Langerhans cells and eosinophils that scars airways and alveoli, leading to cyst formation that can burst leading to pneumothorax
- Langerhans cells are large histiocytes c folded or indented nuclei and abundant eosinophilic cytoplasm
IHC: (+)S100, CD1a, CD207, CD68
Langerhans cells: on EM see Birbeck granules
Genes: serine / threonine (BRAF) activating mutation
- seen in other neoplastic Langerhans cell in other tissue types
Vs Langerhan cell histiocytosis, chronic eosinophilic pneumonia is airspace filling and is composed of alveolar macrophages and eosinophils
- Langerhan cell histiocytosis is interstitial and made of Langerhan cells and eosinophils
Pulmonary Langerhans cell histiocytosis

Erdheim-Chester Disease (ECD)
Rare xanthogranulomatous histiocytosis c lipid-laden histiocytes infiltrating into skeleton and viscera, causing fibrosis in lungs (lung involved in 1/3 cases)
- seen in pts 40-60 yo that have ostalgia, loss of strength and weight, high temp
- bc ECD histiocytes are morphologically and IHC identical to Juvenile Xanthogranuloma (JXG) , has been proposed that ECD is a variant JXG without predominant non-cutaneous involvement
Micro: foamy Touton GCs c fibrosis lymphs, plasma cells and eos
IHC: (+) FXIIIa, CD68, lysozyme in macrophages, S100 + histiocytes
- negative CD1a and langerin (CD207)
Genes: ~1/2 have BRAF V600E mutations
DDx: Langerhans cell histiocytosis (which has S-100 and CD1a + histiocytes)
Tx: may respond to vemurafenib (a BRAF inhibitor)
Characteristic histopathologic and radiographic findings of ECD. (A) PET and (B) 99mTc imaging demonstrating symmetric diametaphyseal radiotracer uptake in the long bones of the legs (arrows) commonly seen in ECD patients. R indicates the patient's right side. (C) CT and (D) MRI scans revealing sclerotic lesions of the metaphyses of femur and tibia (arrows). (E) H&E–stained bx of ECD lesion c lipid-laden histiocytes characteristic of ECD. (F) IHC stain for CD68 revealing positivity of histiocytes.
[Diamond et al. Blood 2014 124:483-492]

Tumors of ectopic origin
Germ cell tumors
Mediastinal seminomas are almost exclusively in males, c majority in 3rd and 4th decades
- although mediastinal embryonal ca occurs in both males and females, it is MC in males
- yolk sac tumors occur MC in females when they occur in prepubertal pts; in postpubertal pts they are almost exclusively in males
Although the possibility of mets should be investigated, mediastinal germ cell tumors thought to arise from extragonadal germ cells in the thymus
Mature and immature teratomas
Mature cystic teratomas are the only mediastinal germ cell tumors that affect males and females equally

Intrapulmonary thymoma
Melanoma
Meningioma, NOS
Metastatic tumors
Pleura Neoplastic
Mesothelioma (malignant)
tumor of the visceral or parietal pleura
MC presenting sign is recurrent idiopathic pleural effusions; smoking is not a risk factor, but can be after long asbestos latency period, or radiation or erionite
- may result in hemorrhagic pleural effusions and pleural thickening
- "sugar icing" (?)
Definitive diagnosis generally requires evidence of invasion into skeletal muscle/adipose tissue on pleural biopsy
•Cannot prove invasion on cytologic effusion specimen!
3 main types:
1) Epithelioid: most common; most effusions
2) Biphasic
3) Sarcomatoid: rarely exfoliates
Gross: thickening of the pleura with tan-white nodules
Micro: biphasic, c spindle / epithelioid cuboidal cells and tubulopapillary parts forming nests or papillae c lots of acidophilic cytoplasm which invades (in rind-like pattern) and is sometimes assoc c necrosis
- Psammoma bodies!!!
- must see invasion, bc otherwise may be mesothelial hyperplasia, which can be florid
- unlike other lung tumors, does not have NE granules
IHC: (+) CK5/6, CK7, WT1, calretinin, podoplanin (D2-40), Alcian blue / colloidal iron (stains hyaluronic acid made by tumor, sensitive to hyaluronidase), vimentin, HMBE-1, N-cadherin, CD146 (MelCAM), CD141 (thrombomodulin, neg in adenoca), PAS (sensitive to diastase)
- negative: CEA, CD15, MOC-31, Ber-EP4, MUC4, TTF-1 [4], napsin A (always neg), CK20, p63, SYN, CHR, BAP-1
- p53, EMA, CD146, and GLUT1 are pos in mesothelioma and neg in reactive mesothelium
EM: long, thin branching microvilli
Genes: clonal chromosomal deletions of 1p, 3q, 6q, 9p, 22q (can test with FISH)
- Homozygous 9p21 deletion has 100% specificity
• p16/CDKN2A tumor suppressor gene
- ~80% of mesotheliomas have some kind of alteration to the BAP-1 gene, which correlates c a loss of IHC expression
Prognosis: poor due to freq mets (has creeping, contiguous spread); rarely has distant mets [4]
- involvement of the mediastinum, such as the pericardium, is common and has a poor px
Tx: combined pneumonectomy + rads + chemo
Well-diff papillary mesothelioma


Mesothelioma types

Biphasic pleural malignant mesothelioma. The biopsy shows a sheet of malignant epithelioid cell proliferation with focal malignant spindle cells (A). The tumor cells are positive for AE1/AE2 (B), calretinin (C), and Wilms tumor 1 (D) (hematoxylin-eosin, original magnification3400 [A];
original magnification3400 [B through D]). [7]


[7]


Mesothelioma


Pleuropulmonary blastoma (PPB)
- embryonal lung and pleural tumor c epithelial (b9) and mesenchymal (low to high grade malignant) parts, usually in early childhood (MC malignancy of lung in childhood, though extremely rare)
- 1/5 are familial, c heterozygous germline mutations in DICER1 which alters miRNA-dependent regulation of diffusable growth
Micro: Type I: purely large cysts lined by single layer of cuboidal to flat epithelium, areas of hypercellularity in wall made of small blue spindly cells, often forming cambium-like layer
- Type 2 and 3 have variable amt solid areas c higher-grade sarcomatous (can be undifferentiated), rhabdomyosarc, or chondrosarc (type 3 is purely solid)
IHC: sometimes shows muscle differentiation, but usually vimentin +
Genes: assoc c gains in cr8 and losses in 9p21 and 11p14
- if familial assoc c DICER1 syndrome (seen in ~40%)
Tx: depends on type; types 2 and 3 get resection and chemo
Px: 5-yr survival 4/5 c type I, 2/5 for types 2 or 3
Pleuropulmonary blastoma - mixed immature solid epithelial and spindle cell elements imparting a biphasic tumor morphology [8]


pleuropulmonary blastom
Sinus histiocytosis with massive lymphadenopathy
- aka Rosai-Dorfman dz
- MC in LNs of head and neck, but also URT, skin, bones CNS, very rare in pleura, usually 1st-2nd decades of life
- histiocytes are not clonal
- may undergo spontaneous resolution
Micro: diffuse histiocyte, lymph, neutrophil infiltration
Solitary Fibrous Tumor
Arise from visceral pleural, but sometimes in lung and lots of other extrathoracic sites
- pts may become hypoglycemic due to paraneoplastic insulin-like growth factor
Attaches with a stump (pedicle) and can grow to be very big, which looks a little like a uterine fibroid in the lung with white whorled fibers
- can have cysts
Micro: patternless pattern of spindle cell prolif c HPC-like branching blood vessels, ropy collagen
Can grade based on necrosis, mitosis and cellular density (inc grade with size, probably)
- malig SFTs characterized by greater cellularity c an infiltrative growth pattern, marked cytologic atypia and high mits (>4 / hpf)
DDx
schwannoma, synovial sarcoma, sarcomatoid carcioma, fibrosarcoma, fibrous histiocytoma
IHC
(+) CD34, bcl2, CD99, STAT6
(-) keratin (always neg), smooth muscle, S100, CD31
Genes: NAB2 and STAT6 fusion on cr 12
Px: slow-growing, usually indolent
- if >2 mits/mm2 with increased cellularity, atypia, or infiltrative growth -> inc rates of recurrence and metastases
sheets of ovoid to spindle cells in a pattern-less pattern with variable cellularity. Background stroma is collagenous

neoplastic cells are uniform, oval to spindle, and without prominent nucleoli. There are no increased mits or necrosis

References
1. Lecture notes, the U
2. Cibas Cytology, ch 2 Respiratory Tract, 3rd ed
3. Sholl, L. Biomarkers in Lung Adenocarcinoma. Arch Pathol Lab Med. April 2015; 139: 469-480
4. Rosai. Surgical Pathology. Ch 7 Respiratory tract. 10th ed
5. Travis, W et al. The 2015 WHO Classification of Lung Tumors. Sep 2015. J Thoracic Oncology. Vol 10 Num 9
6. Mukhopadhyay S and Gal A. Granulomatous Lung Disease: An Approach to the Differential Diagnosis. Arch Pathol Lab Med. May 2010, vol 134 No 5, pp 667-690
7. Woo J et al. Application of Immunohistochemistry in the diagnosis of Pulmonary and Pleural Neoplasms. Arch Pathol Lab Med. Vol 141 Sept 2017.
8. Luther et al. Pleural Tumors Other than Mesothelioma. Archives Pathol Lab Med. Sept 2018.
